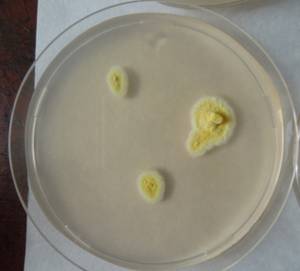
MSU_FS-01853, Район Бу Зяп (Bù Gia Mập district), Bình Phước province (Vietnam)
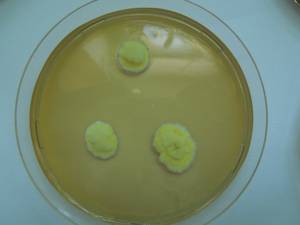
MSU_FS-01629 01, Район Тан Фу (Tân Phú districts), Đồng Nai province (Vietnam)

Total items: 8
Total pages: 1
Organisms

- Specimen ID
- 0000001190034
- Species
- Talaromyces wortmannii
- Strain
- MSU_FS-03457
- Place of isolation
- Район Манг Занг (Mang Yang districts), Gia Lai province (Vietnam)
- Placename
- Адзун (A Yun commune)

- Specimen ID
- 0000000905554
- Species
- Talaromyces wortmannii
- Strain
- MSU_FS-02547
- Place of isolation
- Район Ша Тай (Sa Thầy district), Kon Tum province (Vietnam)
- Placename
- Ро Кой (Rơ Kơi commune)
- Specimen ID
- 0000000904808
- Species
- Talaromyces wortmannii
- Strain
- MSU_FS-01853
- Place of isolation
- Район Бу Зяп (Bù Gia Mập district), Bình Phước province (Vietnam)
- Placename
- Бу Зя Мап (Bù Gia Mập)

- Specimen ID
- 0000000904668
- Species
- Talaromyces wortmannii
- Strain
- MSU_FS-01739
- Place of isolation
- Район Лак (Lắk district), Đắk Lắk province (Vietnam)
- Placename
- Бонг Кранг (Bông Krang)
- Specimen ID
- 0000000904558
- Species
- Talaromyces wortmannii
- Strain
- MSU_FS-01629
- Place of isolation
- Район Тан Фу (Tân Phú districts), Đồng Nai province (Vietnam)
- Placename
- Нам Кат Тьен (Nam Cát Tiên)

- Specimen ID
- 0000000904404
- Species
- Talaromyces wortmannii
- Strain
- MSU_FS-01536
- Place of isolation
- Район Тан Фу (Tân Phú districts), Đồng Nai province (Vietnam)
- Placename
- Нам Кат Тьен (Nam Cát Tiên)

- Specimen ID
- 0000000904104
- Species
- Talaromyces wortmannii
- Strain
- MSU_FS-01319
- Place of isolation
- Район Бао Лам (Bảo Lâm district), Lâm Đồng province (Vietnam)
- Placename
- Лок Бао (Lộc Bảo)

- Specimen ID
- 0000000904102
- Species
- Talaromyces wortmannii
- Strain
- MSU_FS-01318
- Place of isolation
- Район Бао Лам (Bảo Lâm district), Lâm Đồng province (Vietnam)
- Placename
- Лок Бао (Lộc Bảo)